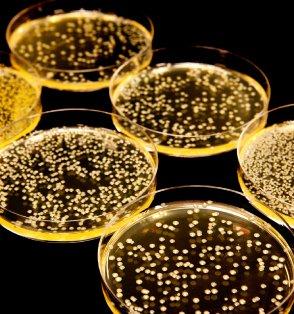

How Microbes Grow
Microbes 101
Dirty surfaces are not only unsightly, they can also harbor bacteria. Keep microbes from logging on to your computer with Fellowes® products featuring Microban® Antimicrobial Protection. When microbes come in contact with the product surface, Microban® protection disrupts the cell so that the microbe cannot grow or reproduce.
For example, in these time lapse photos taken over a 24 hour period with a confocal microscope, you can see how Microban® technology begins to work immediately disrupting the cell so that bacteria are unable to grow or reproduce. While on the unprotected surface, bacteria can quickly multiply and grow.